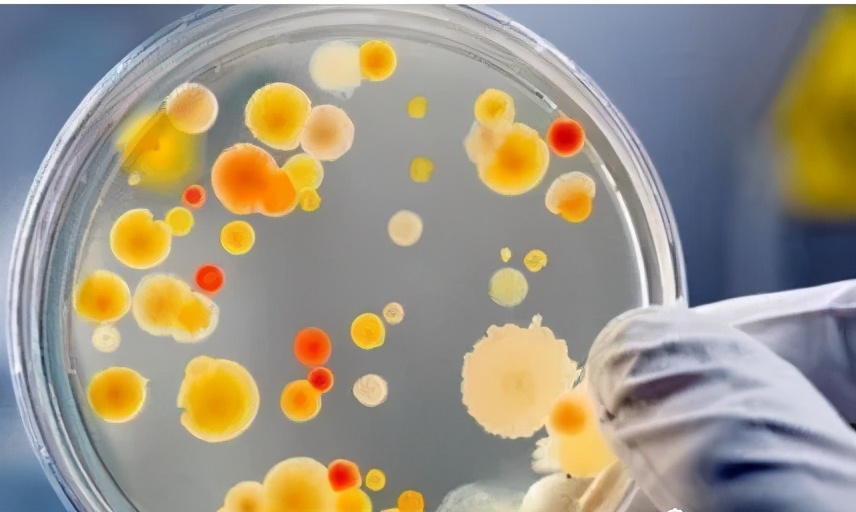
八年级上册生物期末必考的知识点,八年级上册生物性状的遗传知识点

八年级生物:上册知识点总结,保存细看!
更多初中、高中知识,可以在大师一百app中查看,获取哦~
八年级生物上册知识点总结
第一章
一、各种动物的特征:
1.腔肠动物 :身体呈辐射对称;体表有刺细胞;有口无肛门(如海葵、海蛰、珊瑚虫) 2 . 扁形动物 :身体呈两侧对称;背腹扁平;有口无肛门(如涡虫、华枝睾吸虫、日本血吸虫)
3 . 线性动物 :身体细长,呈圆柱形;体表有角质层;有口有肛门(如蛔虫、蛲虫、钩虫、丝虫)
4 . 环节动物 :身体呈圆筒形,有许多彼此相似的体节组成;靠刚毛或疣足辅助运动(如沙蚕、 5 . 软体动物 :柔软的身体表面有外套膜,大多具有贝壳;运动器官是足(如缢蛏、石鳖、蜗牛、鱿鱼、章鱼,乌贼、扇贝、蛾螺等)
6 . 节肢动物 :体表有坚韧的外骨骼;身体和附肢都分节(节肢动物门包括昆虫纲、甲壳纲、蛛形纲、多足纲)
7 . 鱼类 :生活在水中;体表常有鳞片覆盖;用鳃呼吸;通过尾部和躯干部的摆动以及鳍的协调作用游泳
8 . 两栖类 :幼体生活在水中,用鳃呼吸;成体大多生活在陆地上,也可在水中游泳,用肺呼吸,皮肤辅助呼吸
9 . 爬行类 :体表常有角质的鳞片或甲,有肺呼吸,卵生,卵表面有坚硬的外壳
10 . 鸟类 :体表覆羽;前肢变成翼;有喙无齿;有气囊辅助肺呼吸
11 . 哺乳类 :体表被毛;胎生、哺乳;牙齿有门齿、犬齿、臼齿的分化
二、常考的典型动物:
1.蚯蚓

(1)前后、背腹面的区分:前端有环带,而后端没有;背面颜色较深,腹面的颜色较浅。
(2)用手抚摸蚯蚓的体节腹面处,有粗糙不平的感觉。因为腹部有刚毛,可以与肌肉配合运动。
2.蝗虫

(1)全身结构分头部、胸部、腹部三部分,其中头部负责感觉和摄食(1对触角,一对复眼,三个单眼,口器),胸部为运动中心(三对足,两对翅),腹部容纳内脏器官(气管为呼吸器官)。
(2)身体和附肢分节,好处:运动更加的灵活、精巧,从而增强生存能力。
(3)体表有外骨骼,好处:①保护体内柔嫩的器官②防止体内水分的蒸发。
(4)具有三对足,两对翅,好处:扩大了昆虫的活动和分布范围,对于昆虫寻觅食物、躲避敌害、繁殖后代十分有利。
3.鱼

食草:只有门齿和臼齿,无犬齿;消化管很长,盲肠发达。
(2)鱼的体型呈流线型,体表有鳞片覆盖,可以减小鱼在水中运动时遇到的阻力。
(3)鱼呼吸的器官是鳃,最外面是鳃盖,内部是许多鳃丝组成,它的颜色是鲜红色,因为含有大量的毛细血管,有利于进行气体交换。
(4)鱼的运动:通过躯干部和尾部的摆动以及鳍的协调作用来完成。
4、鸟
鸟适于飞行的特征
①外部特征:身体呈流线型;体表覆羽,前肢变翼
②内部结构:胸肌发达,附着胸骨上,胸骨有突起;骨轻、薄、坚固,有些内部中空
③其他特征:视觉发达→消化能力强→双重呼吸(见课本33页图5-28,有气囊辅助肺) → 心跳快,体温高而恒定
5、 哺乳类
食肉,食草、食虫动物牙齿图

食肉:除了有门齿和臼齿外,还有发达的犬齿,用于撕裂食物。
食草:只有门齿和臼齿,无犬齿;消化管很长,盲肠发达。
食虫:门齿尖锐,犬齿不发达,臼齿上有锋利的齿尖
第二章
一、动物的运动
1.运动系统由骨、 关节和肌肉组成,其中骨----杠杆;关节---支点;肌肉-----动力

2.肌肉结构:包括中间较粗的肌腹和两端较细呈乳白色的肌腱,

肌肉特性:肌肉受神经刺激后有收缩的特性,骨骼肌只能收缩牵拉骨而不能推开骨, 所以与骨相连的肌肉至少有两组相互配合活动的。
3.运动的产生过程:在其它系统(消化、呼吸、循环系统)的配合下,当骨骼肌受神经(神经系统)传来的刺激收缩时,会牵动骨头绕关节活动,于是躯体就会产生运动
4.关节的结构图:

(2)青霉孢子:呈扫帚状,颜色为青绿色
关节既牢固又灵活: ①关节囊外有韧带可加固关节;
②关节腔内有滑液可减少摩擦,关节软骨可减少骨与骨的摩擦和缓冲运动带来的震荡。
5.骨、关节、肌肉的协作

一、细菌和真菌的异同点;
伸肘:肱三头肌收缩,肱二头肌舒张。
(双手自然下垂同时处于舒张状态,双手有重物同时处于收缩状态)
二、 动物的行为
1.动物行为:按功能来分:取食行为、攻击行为、防御行为、繁殖行为、迁徙行为等
2.区分动物的先天*行为性**和学习行为: 先天*行为性** 学习行为
获取途径: 生来就会的 后天学习获得的
决定因素: 动物体内的遗传物质决定 遗传因素和环境因素
联系: ①学习行为在先天*行为性**的基础上形成
②学习行为比先天*行为性**高等,能使动物适应更加复杂多变的环境
3、 尝试与错误 是常见的学习行为。动物越高等,学习能力越强,尝试的次数越少。
3.社会行为特征:①群体内部往往形成一定的组织②成员之间有明确的分工 ③有的还形成等级
第三章
1、动物在生物圈中的作用:①维持自然界中 生态平衡 ②促进生态系统的 物质循环 ③帮助植物 传粉、播种
2、生态平衡:在生态系统中各种生物的 数量 和所占的 比例 总是维持在 相对稳定 状态的现象。
3、食物链和食物网中的各种生物之间存在着 相互依赖、相互制约 的关系。其中任一环节出了问题,都会影响整个生态系统。正是由于 物质流 、 能量流 和 信息流 的存在,使各种 生物 与 环境 成为一个统一的整体。
4、生物防治就是利用 生物 来防治病虫害。如用瓢虫杀灭、控制棉蚜数量。主要方法有: 以虫治虫 、 以鸟治虫 、 以菌治虫
5.仿生:科学家通过对动物的认真观察和研究,模方动物的某些结构和功能来发明创造各种仪器设备,这就是仿生。
第四、五章
一、细菌和真菌的异同点;
细菌 真菌
细胞结构 :细胞壁、细胞膜、细胞质、DNA 细胞壁、细胞膜、细胞质、细胞核
外部形态 :是单细胞生物,外形可分 菌体有许多细胞相互连接而成菌丝构成
球菌、杆菌、螺旋菌
营养方式: 异养,大多利用现成的有机物 异养,可利用现成的有机物
生殖方式: 分裂生殖 孢子繁殖,也可进行出芽繁殖
生存条件: 必备有水分、适宜的温度、有机物,有的还需氧气
培养方法: ①配制培养基 ②高温灭菌 ③接种 ④恒温培养
二、细菌、真菌的其他要点:
1.腐生、寄生、共生的区别:
腐生:细菌真菌生活在动植物尸体上,获取有机物的生活方式;
寄生:细菌真菌生活在活的动植物身上,获取有机物的生活方式;
共生:细菌真菌和动植物之间是互助互利的关系。
2.芽孢和孢子的区别:
芽孢:是细菌的休眠体,可适应不良的恶劣环境。孢子:是真菌的生殖细胞,一般在菌丝的顶端。
3.常见食品与细菌、真菌:
酿酒、制作馒头和面包 ------ 酵母菌(真菌);酸奶、泡菜------ 乳酸菌(细菌);
制醋------ 醋酸菌(细菌);制酱------- 霉菌(真菌)
4.“鹅颈瓶”实验:

(1)实验前将肉汤煮沸的目的:杀灭肉汤中细菌、真菌;
(2)甲乙两组实验的变量为:细菌的有无;
(3)乙变质的原因是:空气中的细菌进入到肉汤中。
(4)这个实验证明:细菌是由原已存在的细菌产生的。
5.细胞的结构图:

细胞壁:保护和支持;细胞膜:保护,控制物质的进出;细胞质:加快物质交换;
DNA:内含遗传物质;鞭毛:运动;荚膜:保护;
6.青霉和曲霉图:

大小 :比细菌还小,需借助电子显微镜观察;
(2)青霉孢子:呈扫帚状,颜色为青绿色
曲霉孢子:呈放射状,颜色为黑色
三、病毒的基本特征:
大小 :比细菌还小,需借助电子显微镜观察;
结构 :只有蛋白质外壳和内部遗传物质组成,无细胞结构
生活方式: 不能独立生存,只能寄生在细胞体内
繁殖方式: 利用细胞内物质合成蛋白质外壳,复制自己的遗传物质,形成新的病毒
种类: 根据寄生细胞不同可分:动物病毒、植物病毒、细菌病毒(噬菌体)
与人类的关系: 有害:引起流感等疾病 ;有利:制造疫苗(人工处理的减毒或无毒的病毒)
第六章
一、根据生物的特征进行分类
1、生物分类主要是根据生物的相似程度(包括形态结构和生理功能等)把生物划分为界、门、纲、目、科、属、种从大到小的七个等级,并对每一类群地形态结构和生理功能等特征进行科学的描述,以弄清不同类群之间的 亲缘 关系和 进化 关系。
2、 种 是分类的最基本单位,同种生物的亲缘关系是最密切的。
3、分类单位 越小 ,包含物种 越少 ,而相似特征 越多 ,亲缘关系 最亲密 。
4、植物的主要类群: 藻类植物 、 苔藓植物 、 蕨类植物 、 裸子植物 、 被子植物 。(低等到高等、水生到陆生)
5、被子植物的主要分类依据是: 花、果实、种子
二、生物的多样性
1、生物多样性内涵:它包括三个层次:生物 种类 多样性(即物种多样性), 基因 多样性, 生态系统 的多样性.
2、我国是裸子植物最丰富国家,被称为“ 裸子植物的故乡 ”
3、生物种类多样性,基因多样性,生态系统的多样性三者关系:

生物大师